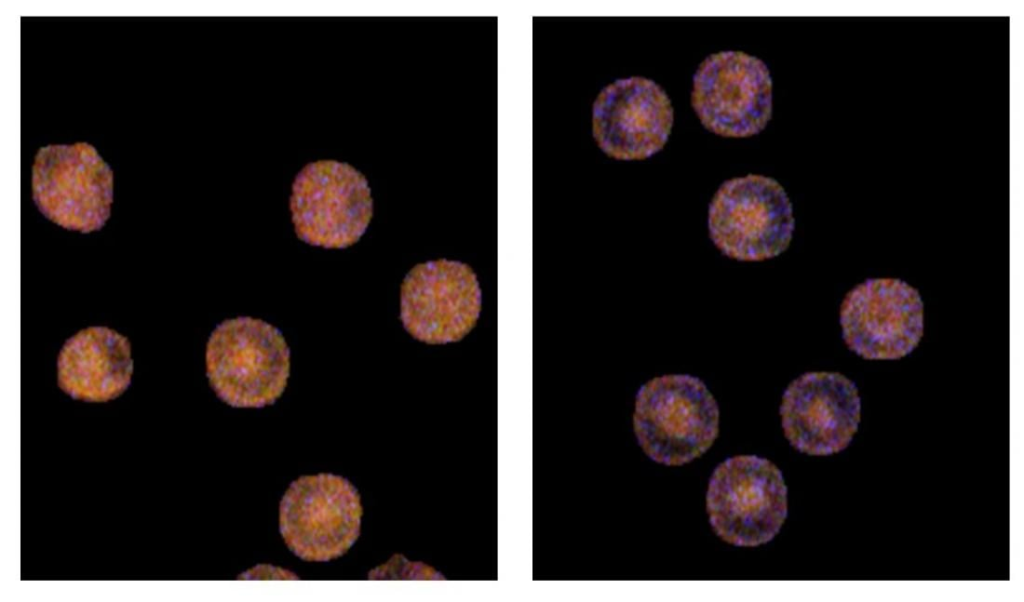

Taipei, October 14, 2025 — A National Taiwan University (NTU) interdisciplinary research team, led by Prof. Chi-Kuang Sun and Prof. Tzung-Dau Wang, has unveiled a groundbreaking optical imaging technique that enables the reconstruction of an individual’s historical blood glucose patterns—information that has long been beyond the reach of current medical technology. This innovation holds transformative potential for diabetes management and early cancer detection. The study was published in Science Advances.
Glycemic variation, reflected through fluctuations in blood glucose levels, is not only a key metric in precision diabetes care but is increasingly recognized as a biomarker for the early detection and risk assessment of several cancers, including pancreatic and gastric cancers. Yet, existing monitoring systems such as continuous glucose monitoring (CGM) can only capture short-term glucose dynamics, leaving past glycemic history undocumented and inaccessible for clinical or research purposes.
Recognizing that circulating red blood cells (RBCs) have varying life spans, the research team discovered that the glycated hemoglobin (HbA1c) content in younger RBCs reflects recent blood glucose levels, while that in older RBCs represents long-term glycemic exposure. By analyzing the distribution of HbA1c across individual RBCs, it becomes possible to retrospectively reconstruct a person’s glycemic trajectory over the entire 120-day lifespan of RBCs.
To realize this concept, the team developed a theoretical RBC glycation model that quantitatively links historical blood glucose changes to single-cell HbA1c distributions. They then translated this model into practice by introducing a pioneering optical imaging technique: color-resolved third-harmonic-generation microscopy (cTHGM).
cTHGM is a label-free, virtually absorption-free chemical imaging technology capable of high-specificity, high-throughput molecular analysis within living cells. Using a wavelength-tunable laser, assisted by NTU alumnus Tzu-Ming Liu, currently a professor at University of Macau, the researchers first jointly demonstrated that a subtle (~2 nm) spectral shift in the Soret absorption band can distinguish HbA1c from normal hemoglobin (Hb) via resonant-enhanced third-harmonic generation (THG).
Building on this principle, NTU developed the broadband femtosecond-laser–based cTHGM system to simultaneously capture THG spectra of HbA1c and Hb within individual RBCs in a single-beam clinical configuration.
The study at NTU hospital successfully demonstrated that cTHGM can noninvasively quantify HbA1c levels in single RBCs both ex vivo and in vivo. Remarkably, the HbA1c distribution measured from a preclinical patient closely matched the theoretical simulation, confirming that cTHGM can reconstruct personal glycemic histories.
“If continuous glucose monitoring is like capturing a two-week video clip of glucose fluctuations, our cTHGM imaging is akin to reviewing the complete surveillance footage covering an entire 120-day RBC lifespan,” said Chi-Kuang Sun, professor of photonics and optoelectronics. “This capability fundamentally changes how we can study and monitor long-term glycemic dynamics,” said Tzung-Dau Wang, professor of internal medicine.
The implications extend far beyond diabetes. By unlocking access to retrospective glycemic information, cTHGM opens new pathways for metabolism-related cancer research, early disease screening, and broader color-sensitive biomedical applications.